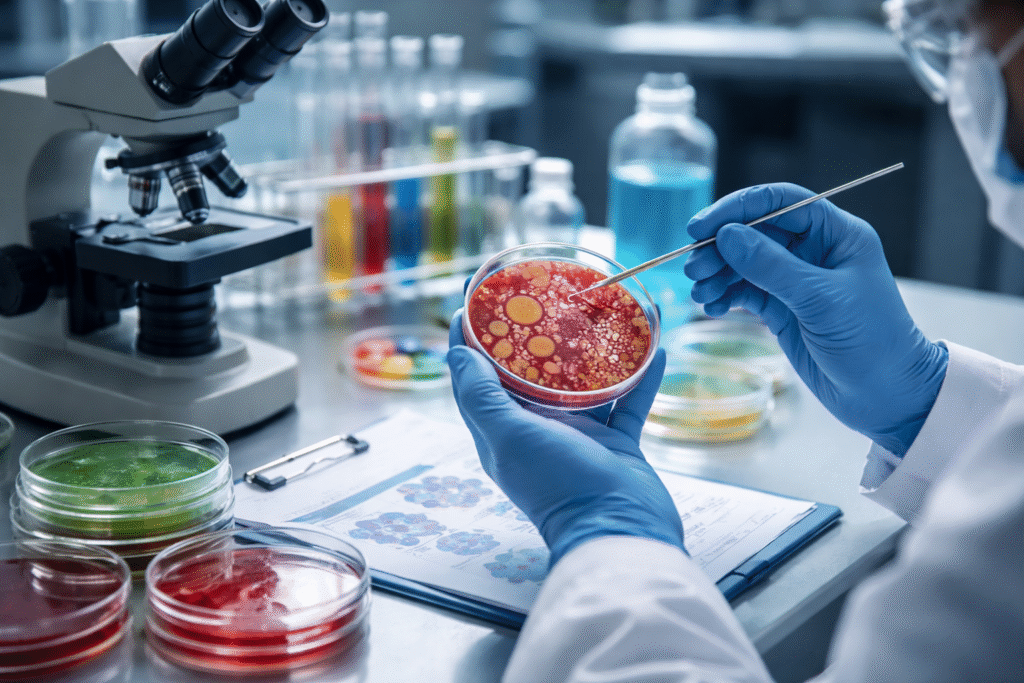

We Employ Latest Research Technology & Company
With strong expertise in chromatographic and spectroscopic techniques, we support industries and researchers with end-to-end analytical support — from sample testing to validated methods and ready-to-use scientific kits.
We focus on quality, regulatory compliance, innovation, and practical skill development, enabling organizations to achieve reliable results and operational excellence.
“At Quenz Analytical LLP, we are pioneering affordable R&D and analytical testing for India’s booming biotech and pharma sectors—empowering SMEs with labs, Collesges & Universities, and contract research at 40-50% lower costs”
Our Expertise
Our laboratory focuses on delivering scientifically validated analytical results with fast turnaround time and complete technical support.
We understand that analytical testing is critical for product quality, regulatory compliance, research validation, and market readiness, and therefore we follow structured analytical workflows and quality-driven practices.

Why People Trust Us
Id elit mauris neque, purus dui turpis gravida id viverra nunc sit risus quam ornare et massa viverra porta risus justo lectus morbi pulvinar non bibendum nisl quisque donec nunc facilisis fermentum.

